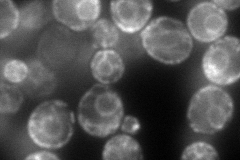
YDR057W
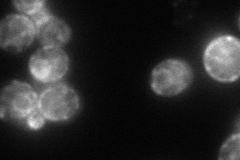
YDR057W
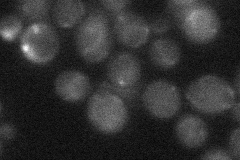
YDR057W
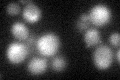
YDR057W

View description
ER quality-control lectin; integral subunit of the HRD ligase; binds to glycans with terminal alpha-1,6 linked mannose on misfolded N-glycosylated proteins and participates in targeting proteins to ERAD; member of the OS-9 protein family
Localization:
Intensity:
Fold change:
Significance:
-
C’ GFP library in SD

below threshold13.68 -
N' NOP1pr-GFP in SD
ER145.515 -
N' TEF2pr-mCherry in SD
ER,punctate98.3335 -
N' NATIVEpr-GFP in SD
below threshold18.9517 -
N' TEF2pr-VC and Cyto-VN in SD

#N/A0 -
C’ GFP library in SD+DTT
cytosolN/AN/ANo -
C’ GFP library in SD+H2O2

cytosolN/AN/ANo -
C’ GFP library in Starvation Media

cytosolN/AN/AYes -
C’ GFP library on the background of Pup2-DaMP

below threshold -
C’ GFP library on the background of CCT mutant

below thresholdN/AN/ANo
